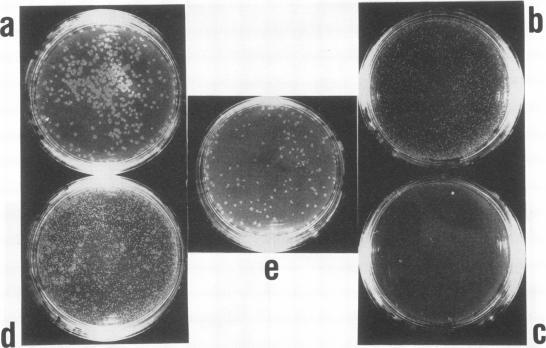
https://cdn.ncbi.nlm.nih.gov/pmc/blobs/54cf/281057/5573caf00b49/iai00021-0064-a.jpg

OmpC参与福氏志贺菌对上皮细胞的侵袭。
OmpC is involved in invasion of epithelial cells by Shigella flexneri.
作者信息
Bernardini M L, Sanna M G, Fontaine A, Sansonetti P J
机构信息
Unité de Pathogénie Microbienne Moléculaire, Institut National de la Santé et de la Recherche Médicale, U 199, Institut Pasteur, Paris, France.
出版信息
Infect Immun. 1993 Sep;61(9):3625-35. doi: 10.1128/iai.61.9.3625-3635.1993.
Osmoregulation of the Shigella flexneri ompC gene and the role of OmpC in Shigella virulence have been investigated. OmpC was highly expressed when bacteria were grown in medium of either low or high osmolarity. This constitutive expression is in contrast with the regulation observed in Escherichia coli, in which the expression of OmpC is repressed at low osmolarity and induced at high osmolarity. In addition, the Shigella ompC gene was barely expressed by a delta ompB (delta ompR and delta envZ) mutant. We described in a previous report that such a mutant was severely impaired in virulence both in vitro and in vivo. Starting from this observation, and in order to assess which gene(s) regulated by ompR and envZ are involved in virulence, we constructed an S. flexneri delta ompC mutant. Three S. flexneri mutants, ompF'-lacZ, delta ompC, and delta ompB, were compared for virulence. The ompF'lacZ mutant behaved like the S. flexneri serotype 5 wild-type strain M90T in all in vitro and in vivo virulence tests. On the contrary, the delta ompB and delta ompC strains were considerably impaired in their virulence phenotypes. The ability of these two mutants to spread from cell to cell and to kill epithelial cells was severely affected. Consequently delta ompC, as previously described for delta ompB, was unable to elicit a positive Sereny test. The delta ompB mutant was restored to virulence by introducing a recombinant multicopy plasmid carrying the cloned E. coli ompC gene, indicating that a functional OmpC protein was necessary and sufficient to restore virulence to this mutant of S. flexneri.
已对福氏志贺氏菌ompC基因的渗透调节作用以及OmpC在志贺氏菌毒力中的作用进行了研究。当细菌在低渗透压或高渗透压培养基中生长时,OmpC会高度表达。这种组成型表达与在大肠杆菌中观察到的调节情况相反,在大肠杆菌中,OmpC的表达在低渗透压下受到抑制,而在高渗透压下被诱导。此外,ompB(ompR和envZ缺失)突变体几乎不表达志贺氏菌ompC基因。我们在之前的一份报告中描述过,这样的突变体在体外和体内的毒力都严重受损。基于这一观察结果,为了评估由ompR和envZ调控的哪些基因参与毒力,我们构建了福氏志贺氏菌ompC缺失突变体。比较了三种福氏志贺氏菌突变体ompF'-lacZ、ompC缺失突变体和ompB缺失突变体的毒力。在所有体外和体内毒力测试中,ompF'lacZ突变体的表现与福氏志贺氏菌5型野生型菌株M90T相似。相反,ompB缺失突变体和ompC缺失突变体的毒力表型严重受损。这两种突变体在细胞间传播和杀死上皮细胞的能力受到严重影响。因此,如之前对ompB缺失突变体的描述,ompC缺失突变体无法引发阳性的塞雷尼试验。通过引入携带克隆的大肠杆菌ompC基因的重组多拷贝质粒,ompB缺失突变体恢复了毒力,这表明功能性的OmpC蛋白对于恢复福氏志贺氏菌该突变体的毒力是必要且充分的。